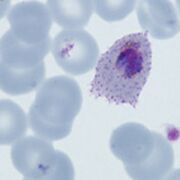
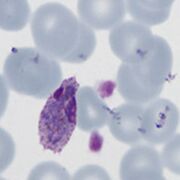
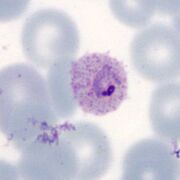
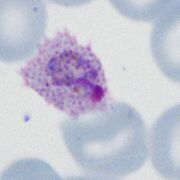
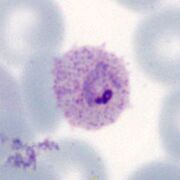

File list
This special page shows all uploaded files.
| Date | Name | Thumbnail | Size | User | Description | Versions |
|---|---|---|---|---|---|---|
| 18:42, 17 May 2024 | Gallery newer.jpg (file) |  |
40 KB | Admin | 1 | |
| 18:28, 17 May 2024 | Thick new.jpg (file) |  |
40 KB | Admin | 1 | |
| 14:30, 17 May 2024 | Thick.jpg (file) |  |
37 KB | Admin | 2 | |
| 11:28, 17 May 2024 | Species new.jpg (file) |  |
73 KB | Admin | 1 | |
| 11:24, 17 May 2024 | Gallery new.jpg (file) |  |
39 KB | Admin | 1 | |
| 14:45, 16 May 2024 | Gallery.jpg (file) |  |
37 KB | Admin | 1 | |
| 14:10, 16 May 2024 | List.jpg (file) |  |
74 KB | Admin | 1 | |
| 14:04, 16 May 2024 | Species.jpg (file) |  |
81 KB | Admin | 1 | |
| 13:59, 16 May 2024 | RDT.jpg (file) |  |
58 KB | Admin | 1 | |
| 13:58, 16 May 2024 | Biology.jpg (file) |  |
40 KB | Admin | 1 | |
| 12:25, 15 May 2024 | New Malaria Lifecycle.jpg (file) |  |
211 KB | Admin | 1 | |
| 11:33, 7 May 2024 | POLT4p.jpg (file) | |
39 KB | Admin | 1 | |
| 11:32, 7 May 2024 | POLT3p.jpg (file) | |
42 KB | Admin | 1 | |
| 11:32, 7 May 2024 | POLT2p.jpg (file) |  |
42 KB | Admin | 1 | |
| 11:32, 7 May 2024 | POLT1p.jpg (file) |  |
55 KB | Admin | 1 | |
| 19:58, 4 May 2024 | POET4p.jpg (file) |  |
48 KB | Admin | 1 | |
| 19:58, 4 May 2024 | POET3p.jpg (file) |  |
40 KB | Admin | 1 | |
| 19:58, 4 May 2024 | POET2p.jpg (file) | |
49 KB | Admin | 1 | |
| 19:56, 4 May 2024 | POET1p.jpg (file) |  |
40 KB | Admin | 1 | |
| 10:23, 2 May 2024 | POG main.jpg (file) |  |
202 KB | Admin | 1 | |
| 10:22, 2 May 2024 | POS main.jpg (file) |  |
113 KB | Admin | 1 | |
| 10:22, 2 May 2024 | POLT main.jpg (file) | |
52 KB | Admin | 1 | |
| 10:22, 2 May 2024 | POET main.jpg (file) | |
46 KB | Admin | 1 | |
| 10:19, 2 May 2024 | POGc.jpg (file) |  |
67 KB | Admin | 1 | |
| 14:00, 29 April 2024 | ExFl4.jpg (file) |  |
43 KB | Admin | 1 | |
| 14:00, 29 April 2024 | ExFl3.jpg (file) |  |
60 KB | Admin | 1 | |
| 14:00, 29 April 2024 | ExFl2.jpg (file) |  |
46 KB | Admin | 1 | |
| 13:59, 29 April 2024 | ExFl1.jpg (file) |  |
64 KB | Admin | 1 | |
| 12:52, 29 April 2024 | Mosquito uptake.jpg (file) |  |
40 KB | Admin | 1 | |
| 11:18, 23 April 2024 | Malaria-Lifecycle.jpg (file) |  |
226 KB | Admin | 2 | |
| 21:00, 20 April 2024 | Liver 3.jpg (file) |  |
127 KB | Admin | 1 | |
| 21:00, 20 April 2024 | Liver 2.jpg (file) |  |
99 KB | Admin | 1 | |
| 20:59, 20 April 2024 | Liver 1.jpg (file) |  |
79 KB | Admin | 1 | |
| 20:59, 20 April 2024 | Liver 0.jpg (file) |  |
82 KB | Admin | 1 | |
| 14:45, 17 April 2024 | Troph.jpg (file) |  |
117 KB | Admin | 1 | |
| 14:44, 17 April 2024 | The schizont.jpg (file) |  |
82 KB | Admin | 1 | |
| 14:44, 17 April 2024 | Blood stages schizonts only.jpg (file) |  |
77 KB | Admin | 1 | |
| 10:48, 12 April 2024 | Malria blood stages.jpg (file) |  |
12 KB | John | 1 | |
| 21:14, 7 April 2024 | PVS main.jpg (file) |  |
46 KB | Admin | 1 | |
| 21:13, 7 April 2024 | PVLT main.jpg (file) |  |
33 KB | Admin | 1 | |
| 21:13, 7 April 2024 | PVG main.jpg (file) |  |
31 KB | Admin | 1 | |
| 21:05, 7 April 2024 | PVS3.jpg (file) |  |
42 KB | Admin | 1 | |
| 21:04, 7 April 2024 | PVS2.jpg (file) |  |
41 KB | Admin | 1 | |
| 21:04, 7 April 2024 | PVS1.jpg (file) |  |
41 KB | Admin | 1 | |
| 21:03, 7 April 2024 | PVG3.jpg (file) |  |
46 KB | Admin | 1 | |
| 21:03, 7 April 2024 | PVG2.jpg (file) |  |
31 KB | Admin | 1 | |
| 21:03, 7 April 2024 | PVG1.jpg (file) |  |
32 KB | Admin | 1 | |
| 17:51, 4 April 2024 | Amoeboid2.jpg (file) |  |
29 KB | Admin | 1 | |
| 17:51, 4 April 2024 | Amoeboid1.jpg (file) |  |
28 KB | Admin | 1 | |
| 10:58, 4 April 2024 | PVLT4.jpg (file) |  |
30 KB | Admin | 1 |